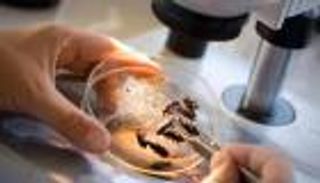
علم الحشرات الجنائي.. أصغر المخلوقات تكشف أهم جرائم القتل والاغتصاب

الحشرات تساهم في كهرباء الغلاف الجوي

عبر قياس المجالات الكهربائية قرب نحل العسل، اكتشف باحثون أن الحشرات يمكن أن تنتج شحنة كهربائية بالغلاف الجوي مثل سحابة العاصفة الرعدية.
ويساعد هذا النوع من الكهرباء في تشكيل أحداث الطقس، ويساعد الحشرات في العثور على الطعام ، ويرفع العناكب في الهواء للهجرة لمسافات كبيرة.
وأظهر البحث، الذي ظهر في 24 أكتوبر/ تشرين الأول في مجلة "آي ساينس"، أن الكائنات الحية يمكن أن يكون لها تأثير على كهرباء الغلاف الجوي.
ويقول المؤلف الأول إلارد هنتينج، عالم الأحياء بجامعة بريستول: "كنا دائمًا ننظر في كيفية تأثير الفيزياء على علم الأحياء، ولكن في مرحلة ما، أدركنا أن البيولوجيا قد تؤثر أيضًا على الفيزياء، ونحن مهتمون بكيفية استخدام الكائنات الحية المختلفة للمجالات الكهربائية الساكنة الموجودة فعليا في كل مكان في البيئة".

وكما هو الحال مع معظم الكائنات الحية، يحمل النحل شحنة كهربائية فطرية، وبعد أن وجد الفريق البحثي أن أسراب خلايا نحل العسل تغير كهرباء الغلاف الجوي بمقدار 100 إلى 1000 فولت لكل متر، مما يزيد من قوة المجال الكهربائي التي يتم اختبارها بشكل طبيعي على مستوى الأرض، طور الفريق نموذجا يمكنه التنبؤ بتأثير الأنواع الأخرى من الحشرات.
ويقول المؤلف المشارك ليام أورايلي، عالم الأحياء بجامعة بريستول: "تأثير أسراب الحشرات على كهرباء الغلاف الجوي يعتمد على كثافتها وحجمها، فلقد حسبنا أيضًا تأثير الجراد على كهرباء الغلاف الجوي، ومن المحتمل أن يكون تأثيره أكبر بكثير من نحل العسل."
ويقول المؤلف المشارك جايلز هاريسون، عالم فيزياء الغلاف الجوي: "اكتشفنا مؤخرا فقط أن علم الأحياء والمجالات الكهربائية الساكنة مرتبطان ارتباطًا وثيقًا، وأن هناك العديد من الروابط غير المتوقعة التي يمكن أن توجد على نطاقات مكانية مختلفة، بدءًا من تفاعلات الميكروبات في التربة وتفاعلات ملقحات النبات إلى أسراب الحشرات، وربما الدائرة الكهربائية العالمية".